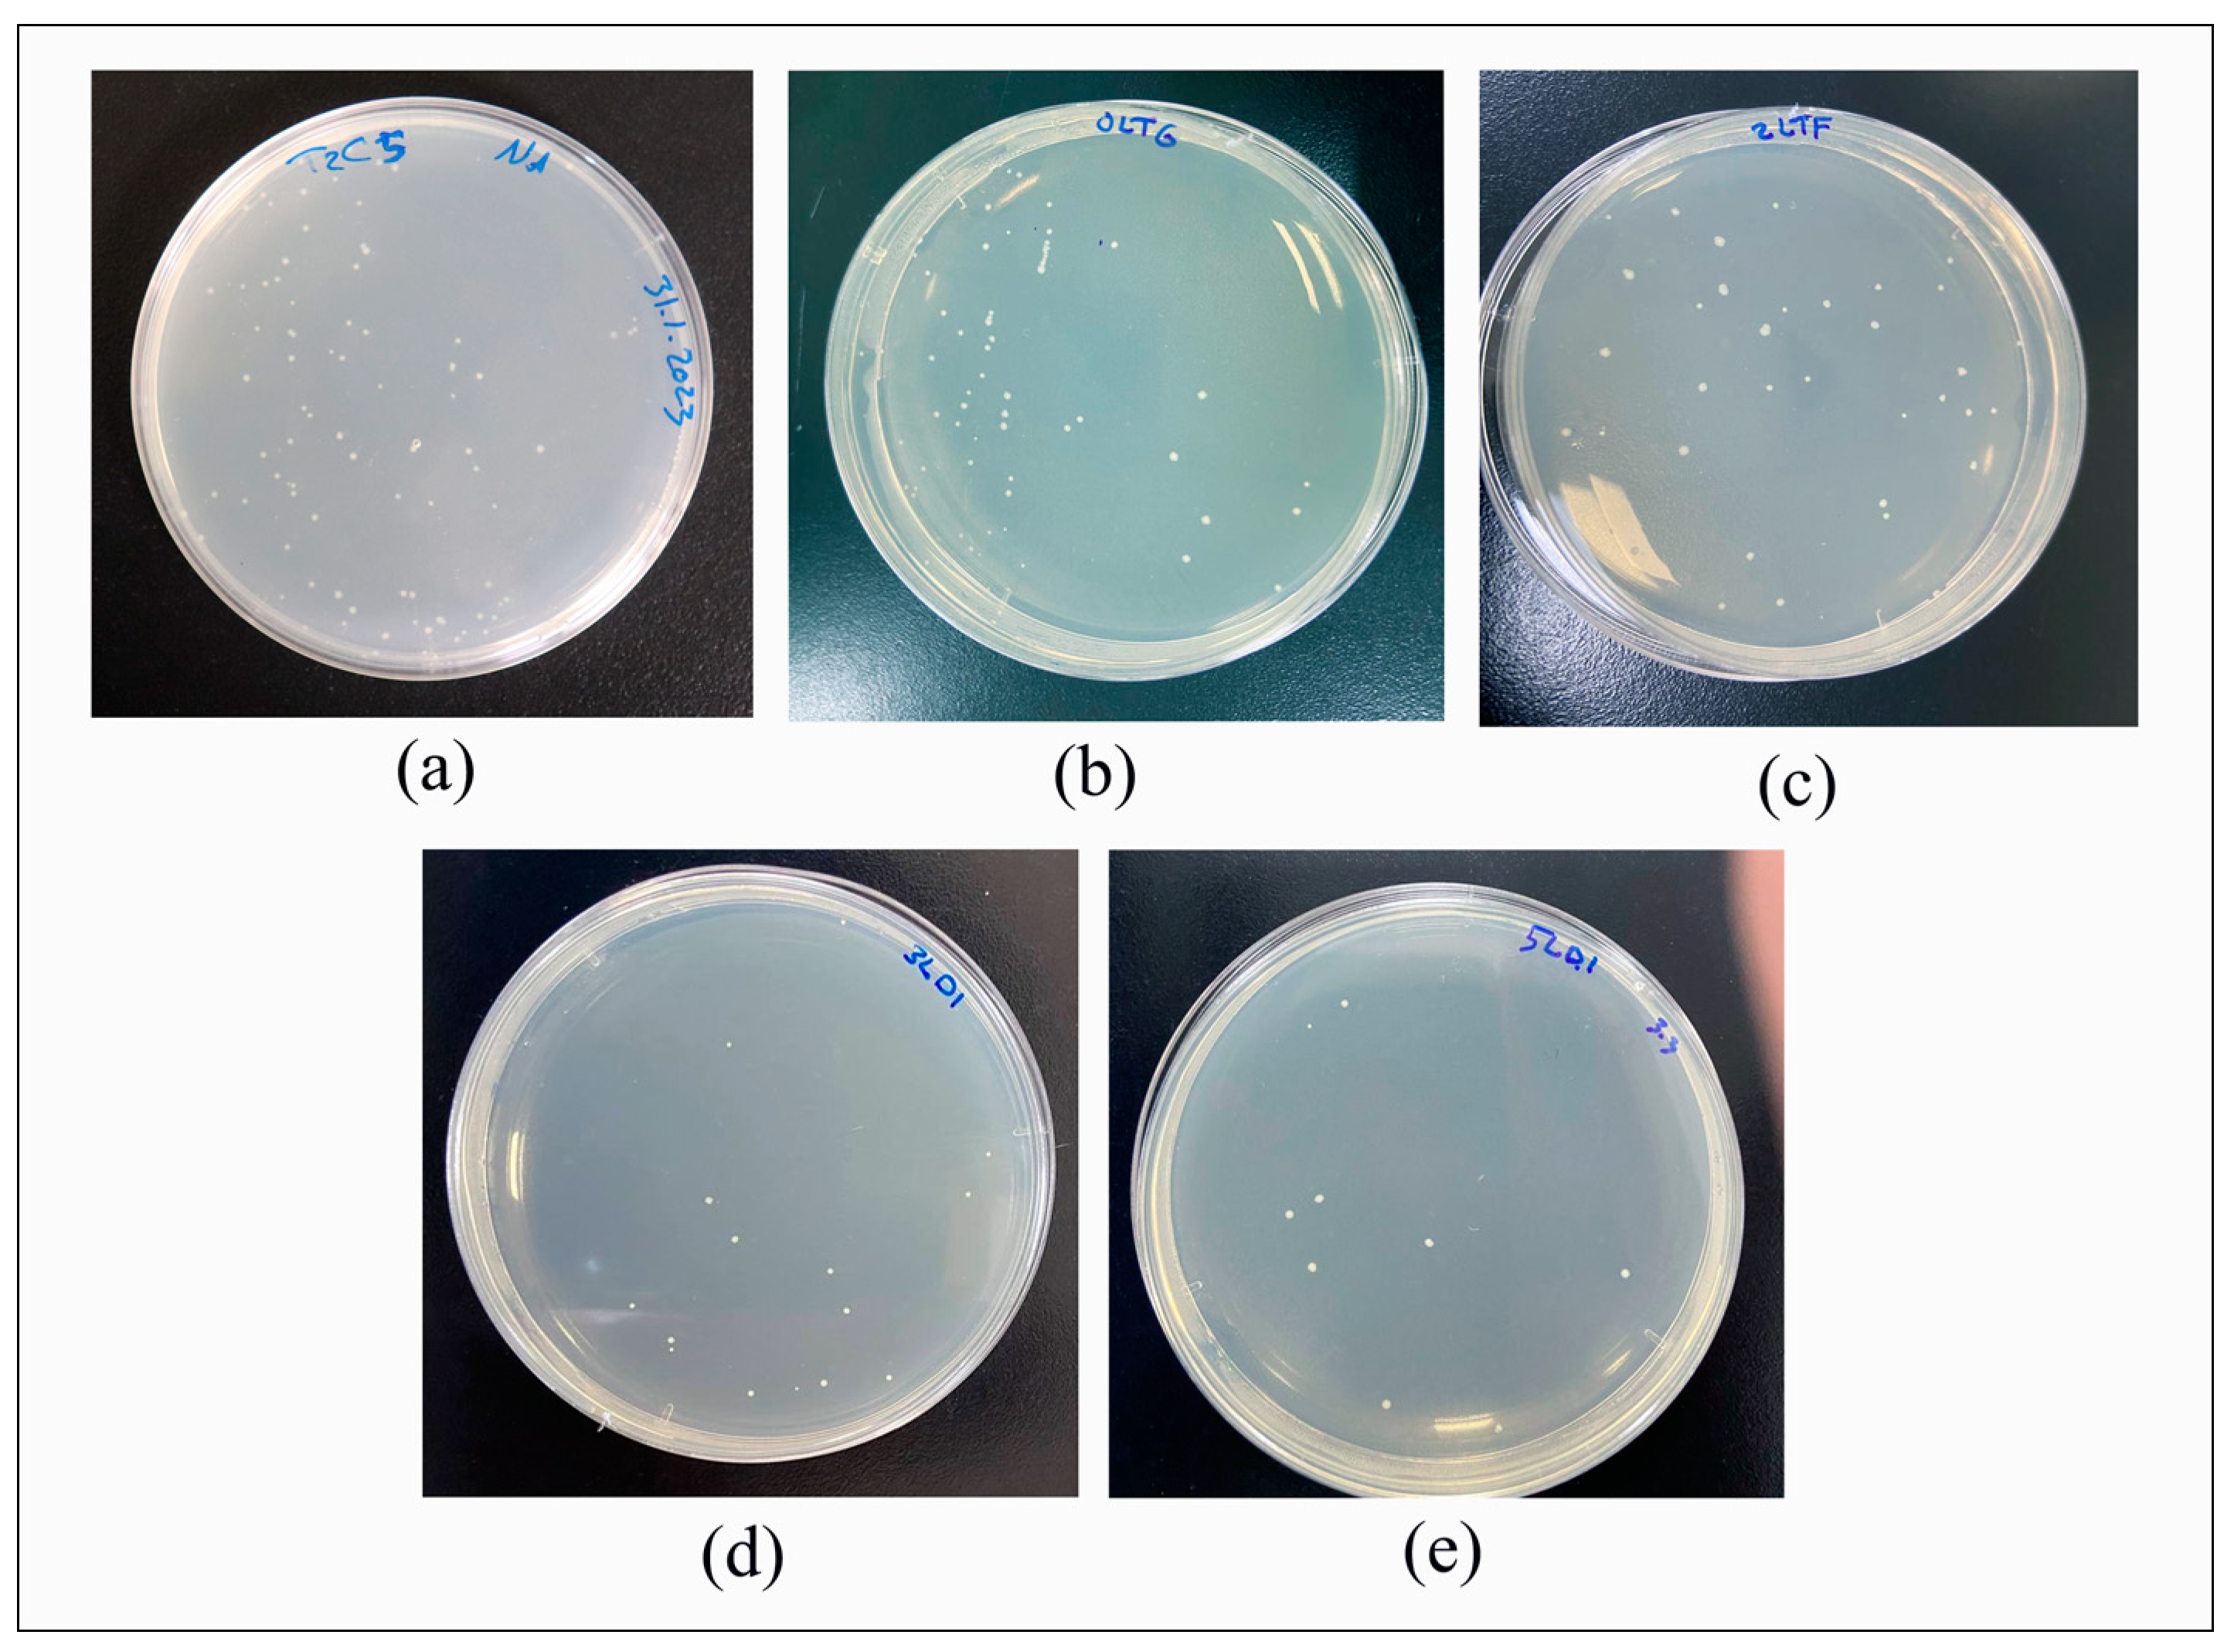
Nanomaterials 13 02649 g004

The Impact of Adding Chitosan Nanoparticles on Biofilm Formation, Cytotoxicity, and Certain Physical and Mechanical Aspects of Directly Printed Orthodontic Clear Aligners
Abstract
:1. Introduction
2. Materials and Methods
2.1. Fabrication of the Specimens
2.2. Antibiofilm Test
2.3. Cytotoxicity Assay
2.3.1. Cell Preparation and Proliferation
2.3.2. Transfer of Cells
2.3.3. Cell Counting and Implantation
2.3.4. MTT Assay
2.3.5. Analysis of Spectrophotometric Data and Cell Viability
2.4. Degree of Conversion
2.5. Accuracy
2.6. Deflection Force
2.7. Tensile Strength
2.8. Statistical Analysis
3. Results
3.1. Antibiofilm
3.2. Cytotoxicity
3.3. Degree of Conversion
3.4. Accuracy
3.5. Deflection Force
3.6. Tensile Strength
4. Discussion
4.1. Antibiofilm
4.2. Cytotoxicity Assay
4.3. Degree of Conversion
4.4. Accuracy
4.5. Deflection Force
4.6. Tensile Strength
5. Conclusions
Author Contributions
Funding
Institutional Review Board Statement
Informed Consent Statement
Data Availability Statement
Acknowledgments
Conflicts of Interest
References
- Rossini, G.; Parrini, S.; Castroflorio, T.; Deregibus, A.; Debernardi, C.L. Efficacy of Clear Aligners in Controlling Orthodontic Tooth Movement: A Systematic Review. Angle Orthod. 2015, 85, 881–889. [Google Scholar] [CrossRef]
- Gu, J.; Tang, J.S.; Skulski, B.; Fields Jr, H.W.; Beck, F.M.; Firestone, A.R.; Kim, D.-G.; Deguchi, T. Evaluation of Invisalign Treatment Effectiveness and Efficiency Compared with Conventional Fixed Appliances Using the Peer Assessment Rating Index. Am. J. Orthod. Dentofac. Orthop. 2017, 151, 259–266. [Google Scholar] [CrossRef]
- Albhaisi, Z.; Al-Khateeb, S.N.; Abu Alhaija, E.S. Enamel Demineralization during Clear Aligner Orthodontic Treatment Compared with Fixed Appliance Therapy, Evaluated with Quantitative Light-Induced Fluorescence: A Randomized Clinical Trial. Am. J. Orthod. Dentofac. Orthop. 2020, 157, 594–601. [Google Scholar] [CrossRef]
- Nasef, A.A.; El-Beialy, A.R.; Mostafa, Y.A. Virtual Techniques for Designing and Fabricating a Retainer. Am. J. Orthod. Dentofac. Orthop. 2014, 146, 394–398. [Google Scholar] [CrossRef]
- Jindal, P.; Worcester, F.; Siena, F.L.; Forbes, C.; Juneja, M.; Breedon, P. Mechanical Behaviour of 3D Printed vs Thermoformed Clear Dental Aligner Materials under Non-Linear Compressive Loading Using FEM. J. Mech. Behav. Biomed. Mater. 2020, 112, 104045. [Google Scholar] [CrossRef]
- Mantovani, E.; Parrini, S.; Coda, E.; Cugliari, G.; Scotti, N.; Pasqualini, D.; Deregibus, A.; Castroflorio, T. Micro Computed Tomography Evaluation of Invisalign Aligner Thickness Homogeneity. Angle Orthod. 2021, 91, 343–348. [Google Scholar] [CrossRef]
- Koenig, N.; Choi, J.-Y.; McCray, J.; Hayes, A.; Schneider, P.; Kim, K.B. Comparison of Dimensional Accuracy between Direct Printed Aligners and Thermoformed Aligners. Korean J. Orthod. 2022, 52, 249–257. [Google Scholar] [CrossRef]
- Tartaglia, G.M.; Mapelli, A.; Maspero, C.; Santaniello, T.; Serafin, M.; Farronato, M.; Caprioglio, A. Direct 3D Printing of Clear Orthodontic Aligners: Current State and Future Possibilities. Materials 2021, 14, 1799. [Google Scholar] [CrossRef]
- Panayi, N. DIY Orthodontics: Design It Yourself; Quintessence Publishing Company Inc.: Batavia, IL, USA, 2021. [Google Scholar]
- Fayyaz Ahamed, S.; Mohnish Kumar, S.; Vijaya Kumar, R.; Apros Kanna, A.; Indrapriyadharshini, K. Cytotoxic Evaluation of Directly 3D Printed Aligners and Invisalign. Eur. J. Mol. Clin. Med 2020, 7, 1129–1140. [Google Scholar]
- Eick, S. Biofilms. Oral Biofilms 2021, 29, 1–11. [Google Scholar] [CrossRef]
- Aranaz, I.; Alcántara, A.R.; Civera, M.C.; Arias, C.; Elorza, B.; Heras Caballero, A.; Acosta, N. Chitosan: An Overview of Its Properties and Applications. Polymers 2021, 13, 3256. [Google Scholar] [CrossRef]
- Deng, P.; Zhou, C.; Wei, Y.; Yue, X.; Li, J.; Yao, L.; Ding, J.; He, Q. Salicylaldehyde Functionalized Chitosan for Electrochemical Sensitive Sensor: Simultaneous Determination of Catechol and Hydroquinone. J. Electroanal. Chem. 2022, 918, 116506. [Google Scholar] [CrossRef]
- Li, J.; Zhuang, S. Antibacterial Activity of Chitosan and Its Derivatives and Their Interaction Mechanism with Bacteria: Current State and Perspectives. Eur. Polym. J. 2020, 138, 109984. [Google Scholar] [CrossRef]
- Ikono, R.; Vibriani, A.; Wibowo, I.; Saputro, K.E.; Muliawan, W.; Bachtiar, B.M.; Mardliyati, E.; Bachtiar, E.W.; Rochman, N.T.; Kagami, H.; et al. Nanochitosan Antimicrobial Activity against Streptococcus Mutans and Candida Albicans Dual-Species Biofilms. BMC Res. Notes 2019, 12, 383. [Google Scholar] [CrossRef]
- Nimbeni, S.B.; Nimbeni, B.S.; Divakar, D.D. Role of Chitosan in Remineralization of Enamel and Dentin: A Systematic Review. Int. J. Clin. Pediatr. Dent. 2021, 14, 562–568. [Google Scholar] [CrossRef]
- Yun, Z.; Qin, D.; Wei, F.; Xiaobing, L. Application of Antibacterial Nanoparticles in Orthodontic Materials. Nanotechnol. Rev. 2022, 11, 2433–2450. [Google Scholar] [CrossRef]
- Lee, J.-H.; Jun, S.-K.; Kim, S.-C.; Okubo, C.; Lee, H.-H. Investigation of the Cytotoxicity of Thermoplastic Denture Base Resins. J. Adv. Prosthodont. 2017, 9, 453–462. [Google Scholar] [CrossRef]
- Lacerda-Santos, R.; Sampaio, G.; Carvalho, F.; Pithon, M.; Guênes, G.; Alves, P. Influence of Degree of Conversion on the Biocompatibility of Different Composites In Vivo. J. Adhes. Dent. 2013, 16, 15–20. [Google Scholar] [CrossRef]
- Moldovan, M.; Balazsi, R.; Soanca, A.; Roman, A.; Sarosi, C.; Prodan, D.; Vlassa, M.; Cojocaru, I.; Saceleanu, V.; Cristescu, I. Evaluation of the Degree of Conversion, Residual Monomers and Mechanical Properties of Some Light-Cured Dental Resin Composites. Materials 2019, 12, 2109. [Google Scholar] [CrossRef]
- Nanda, R.; Castroflorio, T.; Garino, F.; Ojima, K. Principles and Biomechanics of Aligner Treatment-E-Book; Elsevier Health Sciences: Amsterdam, The Netherlands, 2021; ISBN 0-323-68383-5. [Google Scholar]
- Zaghloul, M.M.Y.; Mohamed, Y.S.; El-Gamal, H. Fatigue and Tensile Behaviors of Fiber-Reinforced Thermosetting Composites Embedded with Nanoparticles. J. Compos. Mater. 2019, 53, 709–718. [Google Scholar] [CrossRef]
- Vikash; Kumar, V. Ultrasonic-Assisted de-Agglomeration and Power Draw Characterization of Silica Nanoparticles. Ultrason. Sonochemistry 2020, 65, 105061. [Google Scholar] [CrossRef]
- Formlabs Customer Support. Available online: http://support.formlabs.com/ (accessed on 1 April 2023).
- Resources. Available online: https://www.zenduradental.com/pages/user-resources (accessed on 27 May 2023).
- Alzayyat, S.T.; Almutiri, G.A.; Aljandan, J.K.; Algarzai, R.M.; Khan, S.Q.; Akhtar, S.; Matin, A.; Gad, M.M. Antifungal Efficacy and Physical Properties of Poly(Methylmethacrylate) Denture Base Material Reinforced with SiO2 Nanoparticles. J. Prosthodont. 2021, 30, 500–508. [Google Scholar] [CrossRef]
- Kim, J.-S.; Shin, D.-H. Inhibitory Effect on Streptococcus Mutans and Mechanical Properties of the Chitosan Containing Composite Resin. Restor. Dent. Endod. 2013, 38, 36–42. [Google Scholar] [CrossRef]
- Çakırbay Tanış, M.; Akay, C.; Sevim, H. Cytotoxicity of Long-Term Denture Base Materials. Int. J. Artif. Organs 2018, 41, 677–683. [Google Scholar] [CrossRef]
- ISO 10993-12:2021; Biological Evaluation of Medical Devices—Part 12: Sample Preparation and Reference Materials. Sample Preparation and Reference Materials. ANSI/AAMI: Arlington, TX, USA, 2021.
- Martina, S.; Rongo, R.; Bucci, R.; Razionale, A.V.; Valletta, R.; D’Antò, V. In Vitro Cytotoxicity of Different Thermoplastic Materials for Clear Aligners. Angle Orthod. 2019, 89, 942–945. [Google Scholar] [CrossRef]
- ISO 10993-5:2009; Biological Evaluation of Medical Devices—Part 5: Tests for In Vitro Cytotoxicity. International Organization for Standardization: Geneva, Switzerland, 2009.
- Bationo, R.; Rouamba, A.; Diarra, A.; Beugré-Kouassi, M.L.A.; Beugré, J.; Jordana, F. Cytotoxicity Evaluation of Dental and Orthodontic Light-cured Composite Resins. Clin. Exp. Dent. Res. 2020, 7, 40–48. [Google Scholar] [CrossRef]
- Salehi, S.; Gwinner, F.; Mitchell, J.C.; Pfeifer, C.; Ferracane, J.L. Cytotoxicity of Resin Composites Containing Bioactive Glass Fillers. Dent. Mater. 2015, 31, 195–203. [Google Scholar] [CrossRef]
- Kim, G.-T.; Go, H.-B.; Yu, J.-H.; Yang, S.-Y.; Kim, K.-M.; Choi, S.-H.; Kwon, J.-S. Cytotoxicity, Colour Stability and Dimensional Accuracy of 3D Printing Resin with Three Different Photoinitiators. Polymers 2022, 14, 979. [Google Scholar] [CrossRef]
- Dantagnan, C.-A.; François, P.; Le Goff, S.; Attal, J.-P.; Dursun, E. Degree of Conversion of 3D Printing Resins Used for Splints and Orthodontic Appliances under Different Postpolymerization Conditions. Clin. Oral. Invest. 2023, 27, 2935–2942. [Google Scholar] [CrossRef]
- Lim, J.-H.; Mangal, U.; Nam, N.-E.; Choi, S.-H.; Shim, J.-S.; Kim, J.-E. A Comparison of Accuracy of Different Dental Restorative Materials between Intraoral Scanning and Conventional Impression-Taking: An in Vitro Study. Materials 2021, 14, 2060. [Google Scholar] [CrossRef]
- Son, K.; Jin, M.-U.; Lee, K.-B. Feasibility of Using an Intraoral Scanner for a Complete-Arch Digital Scan, Part 2: A Comparison of Scan Strategies. J. Prosthet. Dent. 2021, 129, 341–349. [Google Scholar] [CrossRef]
- McCarty, M.C.; Chen, S.J.; English, J.D.; Kasper, F. Effect of Print Orientation and Duration of Ultraviolet Curing on the Dimensional Accuracy of a 3-Dimensionally Printed Orthodontic Clear Aligner Design. Am. J. Orthod. Dentofac. Orthop. 2020, 158, 889–897. [Google Scholar] [CrossRef]
- Elkholy, F.; Schmidt, S.; Amirkhani, M.; Schmidt, F.; Lapatki, B.G. Mechanical Characterization of Thermoplastic Aligner Materials: Recommendations for Test Parameter Standardization. J. Healthc. Eng. 2019, 2019, e8074827. [Google Scholar] [CrossRef]
- Albertini, P.; Mazzanti, V.; Mollica, F.; Pellitteri, F.; Palone, M.; Lombardo, L. Stress Relaxation Properties of Five Orthodontic Aligner Materials: A 14-Day In-Vitro Study. Bioengineering 2022, 9, 349. [Google Scholar] [CrossRef]
- Min, S.; Hwang, C.J.; Yu, H.S.; Lee, S.B.; Cha, J.Y. The effect of thickness and deflection of orthodontic thermoplastic materials on its mechanical properties. Korean J. Orthod. 2015, 40, 16–26. [Google Scholar] [CrossRef]
- Tamburrino, F.; D’Antò, V.; Bucci, R.; Alessandri-Bonetti, G.; Barone, S.; Razionale, A.V. Mechanical Properties of Thermoplastic Polymers for Aligner Manufacturing: In Vitro Study. Dent. J. 2020, 8, 47. [Google Scholar] [CrossRef]
- ISO 527-2:2012. Available online: https://www.iso.org/standard/56046.html (accessed on 11 April 2023).
- Edelmann, A.; English, J.D.; Chen, S.J.; Kasper, F.K. Analysis of the Thickness of 3-Dimensional-Printed Orthodontic Aligners. Am. J. Orthod. Dentofac. Orthop. 2020, 158, e91–e98. [Google Scholar] [CrossRef]
- Boyer, R.A.; Kasper, F.K.; English, J.D.; Jacob, H.B. Effect of Print Orientation on the Dimensional Accuracy of Orthodontic Aligners Printed 3-Dimensionally. Am. J. Orthod. Dentofac. Orthop. 2021, 160, 732–742.e1. [Google Scholar] [CrossRef]
- Hosseinnejad, M.; Jafari, S.M. Evaluation of Different Factors Affecting Antimicrobial Properties of Chitosan. Int. J. Biol. Macromol. 2016, 85, 467–475. [Google Scholar] [CrossRef]
- Sahariah, P.; Masson, M. Antimicrobial Chitosan and Chitosan Derivatives: A Review of the Structure–Activity Relationship. Biomacromolecules 2017, 18, 3846–3868. [Google Scholar] [CrossRef]
- Kanimozhi, K.; Basha, S.K.; Kaviyarasu, K.; SuganthaKumari, V. Salt Leaching Synthesis, Characterization and In Vitro Cytocompatibility of Chitosan/Poly(Vinyl Alcohol)/Methylcellulose—ZnO Nanocomposites Scaffolds Using L929 Fibroblast Cells. J. Nanosci. Nanotechnol. 2019, 19, 4447–4457. [Google Scholar] [CrossRef]
- Omura, Y.; Shigemoto, M.; Akiyama, T.; Saimoto, H.; Shigemasa, Y.; Nakamura, I.; Tsuchido, T. Antimicrobial Activity of Chitosan with Different Degrees of Acetylation and Molecular Weights. Biocontrol. Sci. 2003, 8, 25–30. [Google Scholar] [CrossRef]
- Costa, E.M.; Silva, S.; Tavaria, F.K.; Pintado, M.M. Study of the Effects of Chitosan upon Streptococcus Mutans Adherence and Biofilm Formation. Anaerobe 2013, 20, 27–31. [Google Scholar] [CrossRef]
- Ke, C.-L.; Deng, F.-S.; Chuang, C.-Y.; Lin, C.-H. Antimicrobial Actions and Applications of Chitosan. Polymers 2021, 13, 904. [Google Scholar] [CrossRef]
- Mantravadi, P.K.; Kalesh, K.A.; Dobson, R.C.J.; Hudson, A.O.; Parthasarathy, A. The Quest for Novel Antimicrobial Compounds: Emerging Trends in Research, Development, and Technologies. Antibiotics 2019, 8, 8. [Google Scholar] [CrossRef]
- Chandra, H.; Bishnoi, P.; Yadav, A.; Patni, B.; Mishra, A.P.; Nautiyal, A.R. Antimicrobial Resistance and the Alternative Resources with Special Emphasis on Plant-Based Antimicrobials—A Review. Plants 2017, 6, 16. [Google Scholar] [CrossRef]
- Huang, M.; Khor, E.; Lim, L.-Y. Uptake and Cytotoxicity of Chitosan Molecules and Nanoparticles: Effects of Molecular Weight and Degree of Deacetylation. Pharm. Res. 2004, 21, 344–353. [Google Scholar] [CrossRef]
- Xu, Y.; Xepapadeas, A.B.; Koos, B.; Geis-Gerstorfer, J.; Li, P.; Spintzyk, S. Effect of Post-Rinsing Time on the Mechanical Strength and Cytotoxicity of a 3D Printed Orthodontic Splint Material. Dent. Mater. 2021, 37, e314–e327. [Google Scholar] [CrossRef]
- ISO 10993-1; Biological Evaluation of Medical Devices—Part 1: Evaluation and Testing within a Risk Management Process. Available online: https://www.iso.org/obp/ui#iso:std:iso:10993:-1:ed-5:v2:en (accessed on 21 March 2022).
- Nakano, H.; Kato, R.; Kakami, C.; Okamoto, H.; Mamada, K.; Maki, K. Development of Biocompatible Resins for 3D Printing of Direct Aligners. J. Photopolym. Sci. Technol. 2019, 32, 209–216. [Google Scholar] [CrossRef]
- Kwaśny, M.; Bombalska, A.; Obroniecka, K. A Reliable Method of Measuring the Conversion Degrees of Methacrylate Dental Resins. Sensors 2022, 22, 2170. [Google Scholar] [CrossRef]
- Divya, K.; Jisha, M.S. Chitosan Nanoparticles Preparation and Applications. Env. Chem. Lett. 2018, 16, 101–112. [Google Scholar] [CrossRef]
- Song, X.; Chen, Y.; Lee, T.W.; Wu, S.; Cheng, L. Ceramic Fabrication Using Mask-Image-Projection-Based Stereolithography Integrated with Tape-Casting. J. Manuf. Process. 2015, 20, 456–464. [Google Scholar] [CrossRef]
- Lipson, H.; Kurman, M. Fabricated: The New World of 3D Printing; John Wiley & Sons: New York, NY, USA, 2013; ISBN 1-118-41694-5. [Google Scholar]
- Kafle, A.; Luis, E.; Silwal, R.; Pan, H.M.; Shrestha, P.L.; Bastola, A.K. 3D/4D Printing of Polymers: Fused Deposition Modelling (FDM), Selective Laser Sintering (SLS), and Stereolithography (SLA). Polymers 2021, 13, 3101. [Google Scholar] [CrossRef]
- Cortes, A.R.G.; Agius, A.-M.; No-Cortes, J. Factors Affecting Trueness of Intraoral Scans: An Update. Appl. Sci. 2022, 12, 6675. [Google Scholar] [CrossRef]
- Arakida, T.; Kanazawa, M.; Iwaki, M.; Suzuki, T.; Minakuchi, S. Evaluating the Influence of Ambient Light on Scanning Trueness, Precision, and Time of Intra Oral Scanner. J. Prosthodont. Res. 2018, 62, 324–329. [Google Scholar] [CrossRef]
- Oh, H.-S.; Lim, Y.-J.; Kim, B.; Kim, M.-J.; Kwon, H.-B.; Baek, Y.-W. Influence of Scanning-Aid Materials on the Accuracy and Time Efficiency of Intraoral Scanners for Full-Arch Digital Scanning: An In Vitro Study. Materials 2021, 14, 2340. [Google Scholar] [CrossRef]
- Cole, D.; Bencharit, S.; Carrico, C.K.; Arias, A.; Tüfekçi, E. Evaluation of Fit for 3D-Printed Retainers Compared with Thermoform Retainers. Am. J. Orthod. Dentofac. Orthop. 2019, 155, 592–599. [Google Scholar] [CrossRef]
- Nestler, N.; Wesemann, C.; Spies, B.C.; Beuer, F.; Bumann, A. Dimensional Accuracy of Extrusion-and Photopolymerization-Based 3D Printers: In Vitro Study Comparing Printed Casts. J. Prosthet. Dent. 2021, 125, 103–110. [Google Scholar] [CrossRef]
- Yoshidome, K.; Torii, M.; Kawamura, N.; Shimpo, H.; Ohkubo, C. Trueness and Fitting Accuracy of Maxillary 3D Printed Complete Dentures. J. Prosthodont. Res. 2021, 65, 559–564. [Google Scholar] [CrossRef]
- Loflin, W.A.; English, J.D.; Borders, C.; Harris, L.M.; Moon, A.; Holland, J.N.; Kasper, F.K. Effect of Print Layer Height on the Assessment of 3D-Printed Models. Am. J. Orthod. Dentofac. Orthop. 2019, 156, 283–289. [Google Scholar] [CrossRef]
- Revilla-León, M.; Cascos-Sánchez, R.; Zeitler, J.M.; Barmak, A.B.; Kois, J.C.; Gómez-Polo, M. Influence of Print Orientation and Wet-Dry Storage Time on the Intaglio Accuracy of Additively Manufactured Occlusal Devices. J. Prosthet. Dent. 2023. [Google Scholar] [CrossRef] [PubMed]
- Hirogaki, Y.; Sohmura, T.; Satoh, H.; Takahashi, J.; Takada, K. Complete 3-D Reconstruction of Dental Cast Shape Using Perceptual Grouping. IEEE Trans. Med. Imaging 2001, 20, 1093–1101. [Google Scholar] [CrossRef] [PubMed]
- Kohda, N.; Iijima, M.; Muguruma, T.; Brantley, W.A.; Ahluwalia, K.S.; Mizoguchi, I. Effects of Mechanical Properties of Thermoplastic Materials on the Initial Force of Thermoplastic Appliances. Angle Orthod. 2013, 83, 476–483. [Google Scholar] [CrossRef] [PubMed]
- Fang, D.; Zhang, N.; Chen, H.; Bai, Y. Dynamic Stress Relaxation of Orthodontic Thermoplastic Materials in a Simulated Oral Environment. Dent. Mater. J. 2013, 32, 946–951. [Google Scholar] [CrossRef]
- Ryokawa, H.; Miyazaki, Y.; Fujishima, A.; Miyazaki, T.; Maki, K. The Mechanical Properties of Dental Thermoplastic Materials in a Simulated Intraoral Environment. Orthod. Waves 2006, 65, 64–72. [Google Scholar] [CrossRef]
- Kikuchi, L.N.T.; Freitas, S.R.M.; Amorim, A.F.; Delechiave, G.; Catalani, L.H.; Braga, R.R.; Moreira, M.S.; Boaro, L.C.C.; Gonçalves, F. Effects of the Crosslinking of Chitosan/DCPA Particles in the Antimicrobial and Mechanical Properties of Dental Restorative Composites. Dent. Mater. 2022, 38, 1482–1491. [Google Scholar] [CrossRef]
- Al-Harbi, F.A.; Abdel-Halim, M.S.; Gad, M.M.; Fouda, S.M.; Baba, N.Z.; AlRumaih, H.S.; Akhtar, S. Effect of Nanodiamond Addition on Flexural Strength, Impact Strength, and Surface Roughness of PMMA Denture Base. J. Prosthodont. 2019, 28, e417–e425. [Google Scholar] [CrossRef]
- Milovanović, A.; Sedmak, A.; Golubović, Z.; Mihajlović, K.Z.; Žurkić, A.; Trajković, I.; Milošević, M. The Effect of Time on Mechanical Properties of Biocompatible Photopolymer Resins Used for Fabrication of Clear Dental Aligners. J. Mech. Behav. Biomed. Mater. 2021, 119, 104494. [Google Scholar] [CrossRef]
- Husseinsyah, S.; Amri, F.; Husin, K.; Ismail, H. Mechanical and Thermal Properties of Chitosan-Filled Polypropylene Composites: The Effect of Acrylic Acid. J. Vinyl. Addit. Technol. 2011, 17, 125–131. [Google Scholar] [CrossRef]
- Woźniak, A.; Biernat, M. Methods for Crosslinking and Stabilization of Chitosan Structures for Potential Medical Applications. J. Bioact. Compat. Polym. 2022, 37, 151–167. [Google Scholar] [CrossRef]
- Paradowska-Stolarz, A.; Wezgowiec, J.; Malysa, A.; Wieckiewicz, M. Effects of Polishing and Artificial Aging on Mechanical Properties of Dental LT Clear® Resin. J. Funct. Biomater. 2023, 14, 295. [Google Scholar] [CrossRef] [PubMed]

| Ingredients | Percentage |
|---|---|
| Methacrylic oligomer | >70 |
| Glycol methacrylate | <20 |
| Pentamethyl-piperidinyl sebacate | <5 |
| Phosphine oxide | <2.5 |
| Cell Viability | Type of Material | Mean | Std. Deviation | Std. Error | 95% Confidence Interval for Mean | Min. | Max. | |
|---|---|---|---|---|---|---|---|---|
| Lower Bound | Upper Bound | |||||||
| L929 | DW | 100 | 7.81 | 3.49 | 90.3 | 109.7 | 92.18 | 111.69 |
| Polyethylene PE | 88.12 | 18.05 | 8.07 | 65.71 | 110.53 | 70.72 | 111.42 | |
| Thr | 101.8 | 14.11 | 6.31 | 84.27 | 119.32 | 87.82 | 120.41 | |
| CR | 93.86 | 9.86 | 4.41 | 81.61 | 106.10 | 82.65 | 107.77 | |
| CR + 2% Chs | 110.81 | 15.7 | 7.02 | 91.32 | 130.3 | 92.18 | 131.99 | |
| CR + 3% Chs | 95.01 | 12.1 | 5.41 | 79.99 | 110.03 | 82.38 | 111.86 | |
| CR + 5% Chs | 108.26 | 11.04 | 4.94 | 94.55 | 121.97 | 98.47 | 123.44 | |
| ET | 30.55 | 5.30 | 2.37 | 23.97 | 37.13 | 25.29 | 37.94 | |
| 3T3 | DW | 100 | 11.71 | 5.24 | 85.46 | 114.54 | 81.87 | 112.8 |
| PE | 91.85 | 6.4 | 2.86 | 83.91 | 99.8 | 82.07 | 97.8 | |
| Thr | 92.22 | 7.09 | 3.17 | 83.42 | 101.02 | 84.22 | 100.45 | |
| CR | 96.47 | 4.9 | 2.19 | 90.38 | 102.56 | 89.42 | 101.57 | |
| CR + 2% Chs | 85.81 | 8.87 | 3.97 | 74.8 | 96.83 | 78.09 | 100.35 | |
| CR + 3% Chs | 90.67 | 8.19 | 3.66 | 80.5 | 100.84 | 78.4 | 100.55 | |
| CR + 5% Chs | 90.24 | 7.84 | 3.51 | 80.5 | 99.98 | 81.16 | 101.37 | |
| ET | 36.87 | 6.05 | 2.71 | 29.36 | 44.39 | 28.38 | 42.47 | |
| Type of Material | Mean | Std. Deviation | Std. Error | 95% Confidence Interval for Mean | Min. | Max. | |
|---|---|---|---|---|---|---|---|
| Lower Bound | Upper Bound | ||||||
| Thr | 272.23 | 20.3 | 6.42 | 257.72 | 286.75 | 236.8 | 293.81 |
| CR | 235.5 | 1.96 | 0.62 | 234.1 | 236.9 | 233.08 | 239.34 |
| CR + 2% Chs | 237.84 | 8.02 | 2.54 | 232.1 | 243.57 | 223.36 | 251.72 |
| CR + 3% Chs | 239.56 | 2.04 | 0.65 | 238.1 | 241.01 | 235.93 | 241.96 |
| CR + 5% Chs | 245.22 | 1.55 | 0.49 | 244.1 | 246.33 | 243.57 | 248.54 |
| Deflection | Type of Material | Mean | Std. Deviation | Std. Error | 95% Confidence Interval for Mean | Min. | Max. | |
|---|---|---|---|---|---|---|---|---|
| Lower Bound | Upper Bound | |||||||
| 0.25 mm strain | Thr | 8.96 | 0.53 | 0.22 | 8.4 | 9.52 | 8.28 | 9.6 |
| CR | 10.04 | 0.82 | 0.37 | 9.18 | 10.9 | 9.12 | 11.28 | |
| CR + 2% Chs | 10.80 | 0.79 | 0.32 | 9.98 | 11.62 | 9.6 | 11.64 | |
| CR + 3% Chs | 10.06 | 0.74 | 0.3 | 9.29 | 10.83 | 9.12 | 10.92 | |
| CR + 5% Chs | 11.38 | 0.58 | 0.24 | 10.77 | 11.99 | 10.44 | 12.00 | |
| 0.5 mm strain | Thr | 12.38 | 0.62 | 0.25 | 11.73 | 13.03 | 11.64 | 13.32 |
| CR | 14.51 | 2.05 | 0.84 | 12.36 | 16.67 | 12 | 17.04 | |
| CR + 2% Chs | 16.37 | 1.42 | 0.58 | 14.87 | 17.86 | 13.8 | 17.52 | |
| CR + 3% Chs | 15.56 | 2.68 | 1.094 | 12.75 | 18.37 | 12.84 | 18.72 | |
| CR + 5% Chs | 18.72 | 1.39 | 0.57 | 17.26 | 20.18 | 16.32 | 20.4 | |
| Type of Material | Mean | Std. Deviation | Std. Error | 95% Confidence Interval for Mean | Min. | Max. | |
|---|---|---|---|---|---|---|---|
| Lower Bound | Upper Bound | ||||||
| Thr | 47.54 | 3.83 | 1.21 | 44.8 | 50.28 | 42.95 | 55.65 |
| CR | 63.71 | 1.99 | 0.63 | 62.28 | 65.14 | 61.05 | 66.75 |
| CR + 2% Chs | 54.1 | 2.36 | 0.75 | 52.41 | 55.79 | 50.75 | 58.95 |
| CR + 3% Chs | 53.62 | 3.17 | 1 | 51.35 | 55.89 | 49.25 | 57.55 |
| CR + 5% Chs | 48.16 | 3.15 | 1 | 45.91 | 50.41 | 42.6 | 52.1 |
Disclaimer/Publisher’s Note: The statements, opinions and data contained in all publications are solely those of the individual author(s) and contributor(s) and not of MDPI and/or the editor(s). MDPI and/or the editor(s) disclaim responsibility for any injury to people or property resulting from any ideas, methods, instructions or products referred to in the content. |
© 2023 by the authors. Licensee MDPI, Basel, Switzerland. This article is an open access article distributed under the terms and conditions of the Creative Commons Attribution (CC BY) license (https://creativecommons.org/licenses/by/4.0/).
Share and Cite
Taher, B.B.; Rasheed, T.A. The Impact of Adding Chitosan Nanoparticles on Biofilm Formation, Cytotoxicity, and Certain Physical and Mechanical Aspects of Directly Printed Orthodontic Clear Aligners. Nanomaterials 2023, 13, 2649. https://doi.org/10.3390/nano13192649
Taher BB, Rasheed TA. The Impact of Adding Chitosan Nanoparticles on Biofilm Formation, Cytotoxicity, and Certain Physical and Mechanical Aspects of Directly Printed Orthodontic Clear Aligners. Nanomaterials. 2023; 13(19):2649. https://doi.org/10.3390/nano13192649
Chicago/Turabian StyleTaher, Botan Barzan, and Tara Ali Rasheed. 2023. "The Impact of Adding Chitosan Nanoparticles on Biofilm Formation, Cytotoxicity, and Certain Physical and Mechanical Aspects of Directly Printed Orthodontic Clear Aligners" Nanomaterials 13, no. 19: 2649. https://doi.org/10.3390/nano13192649
APA StyleTaher, B. B., & Rasheed, T. A. (2023). The Impact of Adding Chitosan Nanoparticles on Biofilm Formation, Cytotoxicity, and Certain Physical and Mechanical Aspects of Directly Printed Orthodontic Clear Aligners. Nanomaterials, 13(19), 2649. https://doi.org/10.3390/nano13192649

